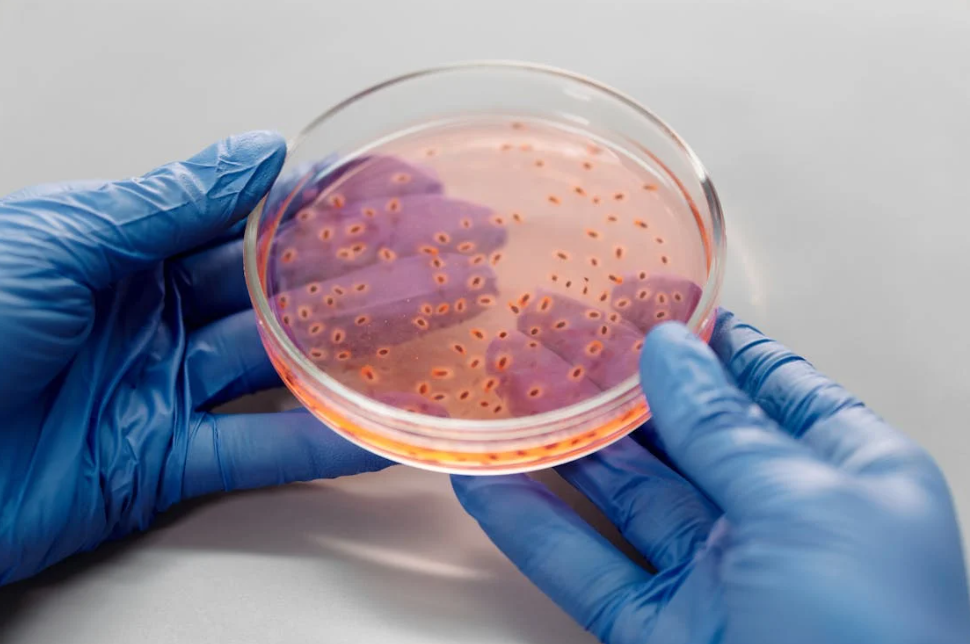

수족구병 대처법, 치료법, 병원 방문 시점, 격리기간 및 어린이집 등원 기준까지 한 번에 정리했습니다. 전염성과 불편함이 큰 수족구병, 미리 알아두면 아이 건강을 지킬 수 있습니다.
🛡️ 수족구병이란?
수족구병은 주로 5세 이하 유아에게 발생하며, 엔테로바이러스에 의해 유발되는 전염성 질환입니다. 여름철에 유행하며, 어린이집 등에서 쉽게 확산됩니다.

🏥 수족구병 대처법
증상 초기에 즉각적인 대처가 중요합니다. 다음과 같은 방법을 우선 적용하세요.
- 체온 체크 및 수분 공급
- 입안 통증 완화를 위한 부드러운 음식 제공
- 손톱을 짧게 잘라 상처 방지
- 전염 방지를 위한 격리 시작
💡 부모의 초기 대응이 회복 속도를 좌

💊 수족구병 치료법
수족구병은 바이러스성 질환이므로 대증 치료가 중심입니다.
- 해열제: 아세트아미노펜 또는 이부프로펜
- 입안 통증 완화: 구강 소독제나 진통제
- 탈수 예방: 미온수, 전해질 보충음료
- 휴식과 수면
❗ 항생제는 효과가 없으며, 사용 금지

🧑⚕️ 수족구병 병원 언제 가야 할까?
다음 증상이 보이면 즉시 병원 진료를 받아야 합니다.
- 고열이 3일 이상 지속
- 소변량 감소, 입술 건조 등 탈수 증상
- 경련이나 의식 저하
- 수포에 진물, 악취 동반
🏥 아이의 이상 반응이 감지되면 즉시 소아과나 응급실로!

🎒 수족구병 어린이집 등원 기준
전염 우려가 있기 때문에 회복 후에도 일정 기간 등원이 제한됩니다.
- 열 완전 회복
- 수포 및 발진 사라짐
- 기타 증상 소실 후 1~2일 경과
📌 최소 7일 이상 격리 필요. 복귀 전 병원 확인서 제출 요구 가능

🧸 수족구병 간호법
집에서도 할 수 있는 간호는 회복에 큰 도움이 됩니다.
- 이마에 찬 수건 대기
- 죽, 요거트 등 부드러운 음식 제공
- 손소독 및 장난감 자주 소독
- 침구 자주 세탁
💡 증상 회복 후 2~3일간은 재감염 주의


🕒 수족구병 격리기간은?
수족구병의 전염성은 증상 사라진 후에도 지속될 수 있어 충분한 격리가 필요합니다.
- 일반 권장 격리기간: 5~7일
- 수포가 모두 사라질 때까지 최대 10일까지 필요할 수 있음
⚠️ 어린이집 복귀 전 담당 기관과 복귀 시점 상담 권장


✅ 정리 요약
수족구병은 전염성이 강한 만큼 조기 대처와 간호, 격리 관리가 핵심입니다. 아이가 아프면 즉시 격리하고, 상태가 악화될 경우 병원에 방문하며, 완쾌 이후에도 등원 기준을 지켜야 주변 감염을 예방할 수 있습니다.
💬 도움이 되셨다면 댓글로 소통해 주세요!
수족구병 초기증상과 잠복기 총정리|아이 열·발진 증상 대처법까지
수족구병 초기증상과 잠복기에 대해 자세히 알아보고, 아이가 갑작스럽게 열이 나거나 손발에 발진이 생겼을 때 어떻게 대응해야 하는지 정리했습니다. 여름철 유행하는 전염병이기 때문에 빠
2.dondondon100.com